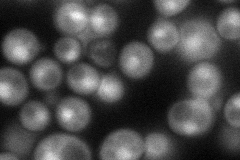
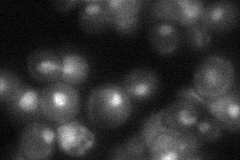
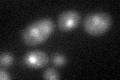

View description
Subunit of both the NuA4 histone H4 acetyltransferase complex and the SWR1 complex, may function to antagonize silencing near telomeres; interacts directly with Swc4p, has homology to human leukemogenic protein AF9, contains a YEATS domain
Localization:
Intensity:
Fold change:
Significance:
-
C’ GFP library in SD

nucleus21.54 -
N' NOP1pr-GFP in SD
cytosol,nucleus78.531 -
N' TEF2pr-mCherry in SD

ERN/A -
N' NATIVEpr-GFP in SD
nucleus25.5191 -
N' TEF2pr-VC and Cyto-VN in SD

#N/A0 -
C’ GFP library in SD+DTT
nucleus23.131.07No -
C’ GFP library in SD+H2O2

nucleus14.390.66Yes -
C’ GFP library in Starvation Media

nucleus21.120.97No -
C’ GFP library on the background of Pup2-DaMP

nucleus -
C’ GFP library on the background of CCT mutant

nucleus21.72621.00782No
